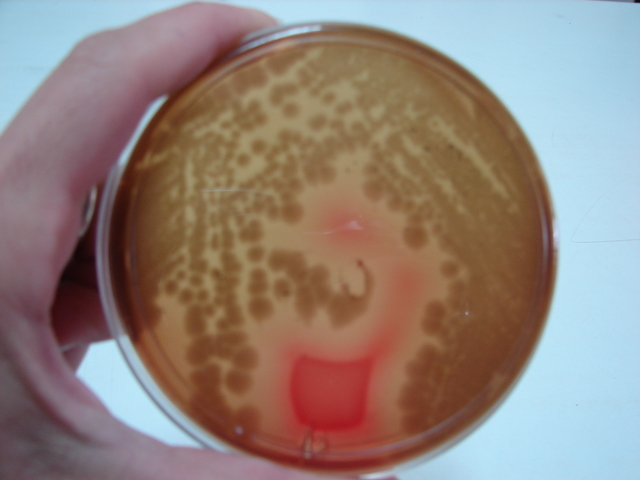
articulo termobacteriologìca

-
Fabrizio Bartletti aisló la lactosa de la leche, Grimaldi separó el gluten de la harina de trigo.
-
Marggraf investigo sobre la remolacha, la presencia en ella de una azúcar idéntico la de la caña de azúcar.
-
sobre la elaboración del vino
(Chaptal)
químico francés -
Kirchhoff demostró la presencia en la malta de una sustancia, que clasifico como una albumina, que era capaz de hidrolizar el almidón.
-
Publico su libro sobre el descubrimiento y puso nombre a las ácidos grasos (Chevruel, francés)
-
Van Houten consiguió extraer la manteca del cacao por prensado.
-
El inglés John Cadbry fabrico por primera vez el chocolate en forma sólida.
-
William Kuhne fue el quien le nombro enzimas.
-
Daniel Peter fabrico por primera vez chocolate con leche
-
Se empezó trasportarse mantequilla y queso refrigerados desde Australia y gran Bretaña.
-
primera edición de la compilación de métodos de la AOAC.
-
Funk consiguió aislar de la cascarilla de la arroz de una sustancia que era capaz de curarlo y prevenirlo.
-
Bigelow y Esty publicaron un artículo en el que sentaban las bases de la termobacteriología tal como la conocemos actualmente-
-
Du Pont comienza a comercializar el celofán.
-
fundo la empresa birdseye seafood inc. Comenzando en 1925 la comercialización de filetes de pescados congelado.
-
Alemania se instaló el primer túnel de congelación.
-
Crocker, Hitchcock y Zimmerman plantearían el papel de esta sustancia como hormona vegetal.
-
publicaron el primer análisis correcto de la composición de aminoácidos de una proteína. (Brand).
-
comienza a utilizarse el aluminio para la fabricación de latas.
-
comenzó la comercialización de la primera proteína animal.
Looking for a timeline maker?
Create timelines for projects, roadmaps, history, lessons, legal cases, and stories with Timetoast. Timetoast is a timeline maker for work, school, research, and stories.